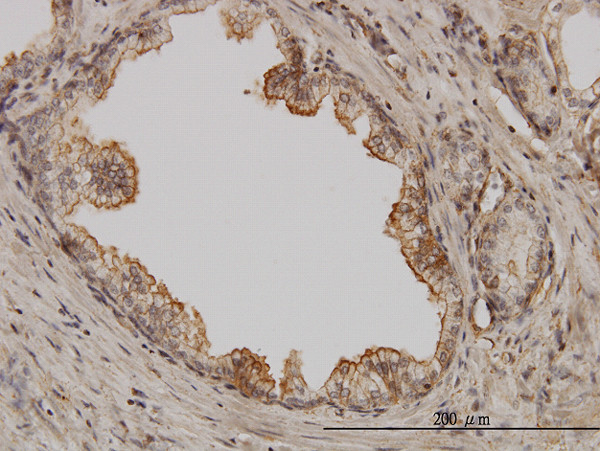
PAK1 Antibody in Immunohistochemistry (Paraffin) (IHC (P))

Search
Abnova
PAK1 Monoclonal Antibody (1E11)
{{$productOrderCtrl.translations['antibody.pdp.commerceCard.promotion.promotions']}}
{{$productOrderCtrl.translations['antibody.pdp.commerceCard.promotion.viewpromo']}}
{{$productOrderCtrl.translations['antibody.pdp.commerceCard.promotion.promocode']}}: {{promo.promoCode}} {{promo.promoTitle}} {{promo.promoDescription}}. {{$productOrderCtrl.translations['antibody.pdp.commerceCard.promotion.learnmore']}}
产品信息
H00005058-M01
种属反应
宿主/亚型
分类
类型
克隆号
抗原
偶联物
形式
浓度
规格
纯化类型
保存液
内含物
保存条件
运输条件
产品详细信息
Sequence of this protein is as follows: APRPEHTKSV YTRSVIEPLP VTPTRDVATS PISPTENNTT PPDALTRNTE KQKKKPKMSD EEILEKLRSI VSVGDPKKKY TRFEKIGQGA
靶标信息
PAK1 is a serine/threonine kinase that is a target for restenosis, cancer, and immunosuppression treatment. These proteins serve as targets for the small GTP binding proteins Cdc42 and Rac and have been implicated in a wide range of biological activities. PAK1 regulates cell motility and morphology.
仅用于科研。不用于诊断过程。未经明确授权不得转售。
篇参考文献 (0)
生物信息学
蛋白别名: ADRB2; alpha pak; Alpha-PAK; EC 2.7.11.1; kinase PAK1; MGC130000; MGC130001; p21 protein (Cdc42/Rac)-activated kinase 1; p21-activated kinase 1; p21/Cdc42/Rac1-activated kinase 1 (STE20 homolog, yeast); p21/Cdc42/Rac1-activated kinase 1 (yeast Ste20-related); p65-PAK; PAK 1; PAK-1; PAK1B; protein kinase; Serine/threonine-protein kinase PAK 1; STE20 homolog, yeast; unnamed protein product
基因别名: alpha-PAK; IDDMSSD; p65-PAK; PAK1; PAKalpha
UniProt ID: (Human) Q13153
Entrez Gene ID: (Human) 5058